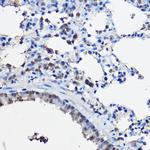
SRC2 Antibody in Immunohistochemistry (Paraffin) (IHC (P))

Search
Invitrogen
SRC2 Polyclonal Antibody
{{$productOrderCtrl.translations['antibody.pdp.commerceCard.promotion.promotions']}}
{{$productOrderCtrl.translations['antibody.pdp.commerceCard.promotion.viewpromo']}}
{{$productOrderCtrl.translations['antibody.pdp.commerceCard.promotion.promocode']}}: {{promo.promoCode}} {{promo.promoTitle}} {{promo.promoDescription}}. {{$productOrderCtrl.translations['antibody.pdp.commerceCard.promotion.learnmore']}}
图: 1 / 4
SRC2 Antibody (PA5-120079) in IHC (P)

产品信息
PA5-120079
种属反应
宿主/亚型
分类
类型
抗原
偶联物
形式
浓度
规格
纯化类型
保存液
内含物
保存条件
运输条件
RRID
产品详细信息
Positive test controls include: 293T, BT-474. The target is usually found in the following locations: Nucleus.
Immunogen sequence: SSLASPDLKM GNLQNSPVNM NPPPLSKMGS LDSKDCFGLY GEPSEGTTGQ AESSCHPGEQ KETNDPNLPP AVSSERADGQ SRLHDSKGQT KLLQLLTTKS DQMEPSPLAS SLSDTNKDST GSLPGSGSTH GTSLKEKHKI LHRLLQDSSS PVDLAKLTAE ATGKDLSQES SSTAPGSEVT IKQEPVSPKK KENALLRYLL DKDDTKDIGL PEITPKLERL DSKTDPASNT KLIAMKTEKE EMSFEPGDQP GSELDNLEEI LDDLQNSQLP Q
靶标信息
SRC2 (steroid receptor coactivator 2), also known as nuclear receptor coactivator2, NCOA2 or TIF2, aids in the function of nuclear hormone receptors. Nuclear hormone receptors are conditional transcription factors that play important roles in various aspects of cell growth, development, and homeostasis by controlling expression of specific genes. Members of the nuclear hormone receptor superfamily, which includes the 5 steroid receptors and class II nuclear receptors, are structurally characterized by 3 distinct domains: an N-terminal transcriptional activation domain, a central DNA-binding domain, and a C-terminal hormone-binding domain. Before the binding of hormone, steroid receptors, which are sometimes called class I of the nuclear hormone receptor family, remain inactive in a complex with heat-shock protein-90 and other stress family proteins. Binding of hormone induces critical conformational changes in steroid receptors that cause them to dissociate from the inhibitory complex, bind as homodimers to specific DNA enhancer elements associated with target genes, and modulate that gene's transcription. After binding to enhancer elements, transcription factors require transcriptional coactivator proteins to mediate their stimulation of transcription initiation.
仅用于科研。不用于诊断过程。未经明确授权不得转售。
篇参考文献 (0)
生物信息学
蛋白别名: bHLHe75; c-fgr; c-src2; Class E basic helix-loop-helix protein 75; FLJ43153; glucocorticoid receptor-interacting protein-1; hTIF2; MGC75096; NCoA-2; Nuclear receptor coactivator 2; p160 steroid receptor coactivator 2; p55c-fgr; p58c-fgr; TIF 2; Transcriptional intermediary factor 2; unnamed protein product
基因别名: BHLHE75; GRIP1; KAT13C; NCoA-2; NCOA2; SRC2; TIF2
UniProt ID: (Human) Q15596, (Rat) Q9WUI9
Entrez Gene ID: (Human) 10499, (Rat) 83724




